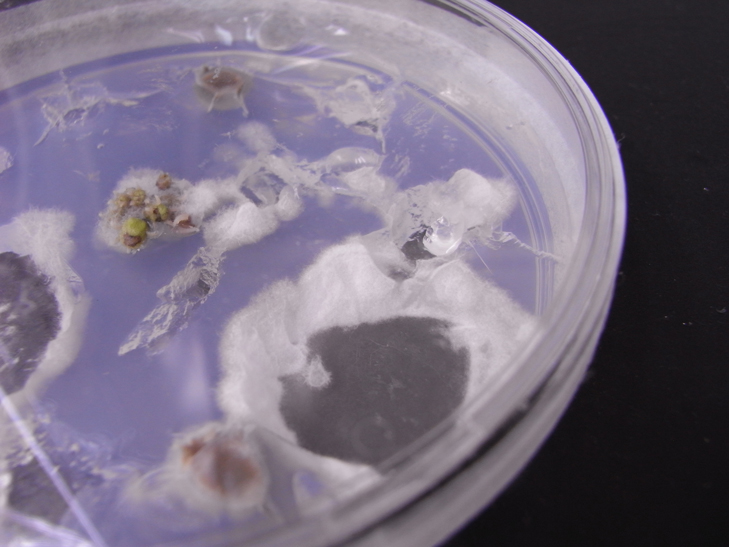
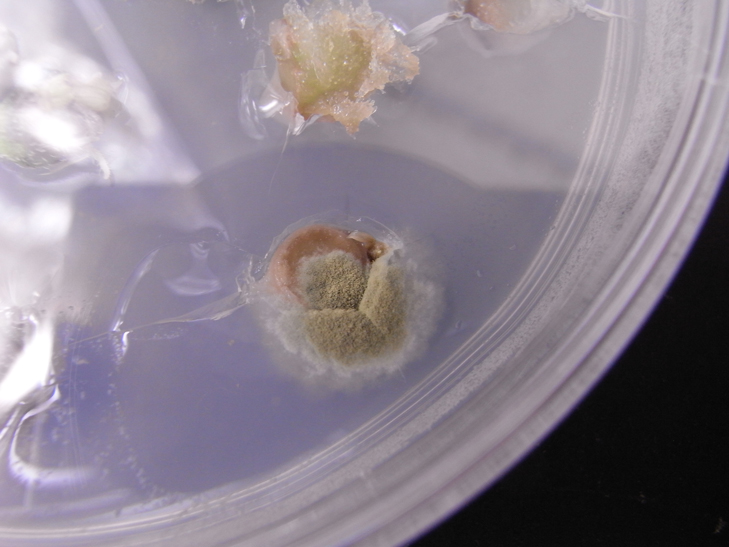

本家"CropWorks"の近況用blog
本家:http://cropworks.orz.hm/index.htm
農工大Bn科の過去問集積&管理業務。
同人サークル「農工植研」の活動。
管理人Sr38のPC関連覚書。
あと絵とか写真とか。
本家:http://cropworks.orz.hm/index.htm
農工大Bn科の過去問集積&管理業務。
同人サークル「農工植研」の活動。
管理人Sr38のPC関連覚書。
あと絵とか写真とか。
×
[PR]上記の広告は3ヶ月以上新規記事投稿のないブログに表示されています。新しい記事を書く事で広告が消えます。
最近はひたすら植物片を滅菌して抗生物質フリーで組織培養。
が、プレート一枚分完全に滅菌できてるのは半分にも満たないorz
実際できてるのもあるのだから多分威力は十分なんだろう。
プロならもっと上手くできるのだろうか。
今日の除去作業はオールスターな感じだった。
しろいかび
しろいかび
 はいいろのかび
はいいろのかび
 あかいかび
あかいかび
みどりのかび
みどりのかび
イエローはこの前捨てた(´・ω・`)カレー好きね。
カビは早めに処理しないと1シャーレ全滅の危険性高。
シャーレ外周で発生するのはコンタミなんだろうな。
培地は除去して、外壁は熱したメスを押し付けて申し訳程度に殺菌してる。
培地が熱で液状化したら完全に全滅フラグ。
植物片からでてくるのはカビよりむしろ細菌?みたいなのが多い(´・ω・)スネ
植物片を埋め込んだときの亀裂にそってもやもや増殖するやつ。
こいつはあんまり進行しないから基本放置してまつ(´・ω・`)
・Web拍手れす
>大丈夫、このまま行けばきっと君が社会的勝者だ。
自信ないっす…(´・ω・`)でもやるしかねっすね。もうもどれねーですもん。
おっくせんまん。
が、プレート一枚分完全に滅菌できてるのは半分にも満たないorz
実際できてるのもあるのだから多分威力は十分なんだろう。
プロならもっと上手くできるのだろうか。
今日の除去作業はオールスターな感じだった。
イエローはこの前捨てた(´・ω・`)カレー好きね。
カビは早めに処理しないと1シャーレ全滅の危険性高。
シャーレ外周で発生するのはコンタミなんだろうな。
培地は除去して、外壁は熱したメスを押し付けて申し訳程度に殺菌してる。
培地が熱で液状化したら完全に全滅フラグ。
植物片からでてくるのはカビよりむしろ細菌?みたいなのが多い(´・ω・)スネ
植物片を埋め込んだときの亀裂にそってもやもや増殖するやつ。
こいつはあんまり進行しないから基本放置してまつ(´・ω・`)
・Web拍手れす
>大丈夫、このまま行けばきっと君が社会的勝者だ。
自信ないっす…(´・ω・`)でもやるしかねっすね。もうもどれねーですもん。
おっくせんまん。
PR
楽天からメールキタ━━━━(゚∀゚)━━━━ !!!!!
と思いきや。
----------------------------------------------------------------
■商品はまだ店舗に到着しておりません
----------------------------------------------------------------
当メールは、ご注文商品を運送会社へ引き渡しを行ったご案内のメールです。
店舗での受取開始予定日は、当メールの2~4日後に配信される、
「【楽天ブックス】商品がコンビニへ到着しました」メールに
記載しております。メール配信まで、今しばらくお待ちください。
ハァァアア!?
2~4日後って何なの?馬鹿なの?死ぬの?
1日後に到着メール出せる可能性がゼロなことに絶望した。
それにしても遅い。
これは果たしてコンビニ受取が悪いのか。
それとも楽天ブックス自体が悪いのか。
メールが25:20に着てるあたり、楽天が悪いような気がしてきている。
通販はフラゲができる夢の購入方法だと思っていた時期が(ry (冗談ですが
電車代とか近隣の書店に入荷がなかった場合を想定すると仕方ないかなーとも思うけど。
通販自体殆ど使わないからよくわかんないな。
とりあえず宅急便の受取とか雨天とかで結構自宅にいられたもので
自宅配送にしておけばよかったなーと思う今日この頃。
と思いきや。
----------------------------------------------------------------
■商品はまだ店舗に到着しておりません
----------------------------------------------------------------
当メールは、ご注文商品を運送会社へ引き渡しを行ったご案内のメールです。
店舗での受取開始予定日は、当メールの2~4日後に配信される、
「【楽天ブックス】商品がコンビニへ到着しました」メールに
記載しております。メール配信まで、今しばらくお待ちください。
ハァァアア!?
2~4日後って何なの?馬鹿なの?死ぬの?
1日後に到着メール出せる可能性がゼロなことに絶望した。
それにしても遅い。
これは果たしてコンビニ受取が悪いのか。
それとも楽天ブックス自体が悪いのか。
メールが25:20に着てるあたり、楽天が悪いような気がしてきている。
通販はフラゲができる夢の購入方法だと思っていた時期が(ry (冗談ですが
電車代とか近隣の書店に入荷がなかった場合を想定すると仕方ないかなーとも思うけど。
通販自体殆ど使わないからよくわかんないな。
とりあえず宅急便の受取とか雨天とかで結構自宅にいられたもので
自宅配送にしておけばよかったなーと思う今日この頃。
ご心配おかけしましたorz
まぁあれです。いつもの周期的鬱です。
今回はお気に入りのぼっちスポットを開拓するぐらいの鬱です。
これは過去最高値なんじゃないかと思う今日この頃。
このレベルになると周りがリア充に見えてきて
うっかり発言で人生崩壊しそうです。
なんというか、サルモネラ菌in鶏卵内部とか、
欠陥部品組み込んで本体お亡くなりとか、
攻略順番知らずに筋肉エンドとか、
そういった地獄直行肩透かし系の理不尽な。
いったいどういった用心深さがあればその地雷踏まないんだと。
それでもきっと自分のせいだから困る。
あとね、観測されない事象に意味も価値もないわけで。
・Web拍手れす
>参事ってなんだ?
隠語。三次元→賛辞、惨事など。二次元→虹なら一般的すね。
>なにがあったね
ご心配おか(ry
絶賛絶望中。もうね、次の人生にご期待ください感漂う。
でも俺の閾値高すぎるから大丈夫ぃ。
むしろきみの方が心配になってくる書き物をしているというか。
まぁあれです。いつもの周期的鬱です。
今回はお気に入りのぼっちスポットを開拓するぐらいの鬱です。
これは過去最高値なんじゃないかと思う今日この頃。
このレベルになると周りがリア充に見えてきて
うっかり発言で人生崩壊しそうです。
なんというか、サルモネラ菌in鶏卵内部とか、
欠陥部品組み込んで本体お亡くなりとか、
攻略順番知らずに筋肉エンドとか、
そういった地獄直行肩透かし系の理不尽な。
いったいどういった用心深さがあればその地雷踏まないんだと。
それでもきっと自分のせいだから困る。
あとね、観測されない事象に意味も価値もないわけで。
・Web拍手れす
>参事ってなんだ?
隠語。三次元→賛辞、惨事など。二次元→虹なら一般的すね。
>なにがあったね
ご心配おか(ry
絶賛絶望中。もうね、次の人生にご期待ください感漂う。
でも俺の閾値高すぎるから大丈夫ぃ。
むしろきみの方が心配になってくる書き物をしているというか。
何かがおかしいというか、何もかもがおかしい。
もう参事はだめかもわからんね。
もう参事はだめかもわからんね。
